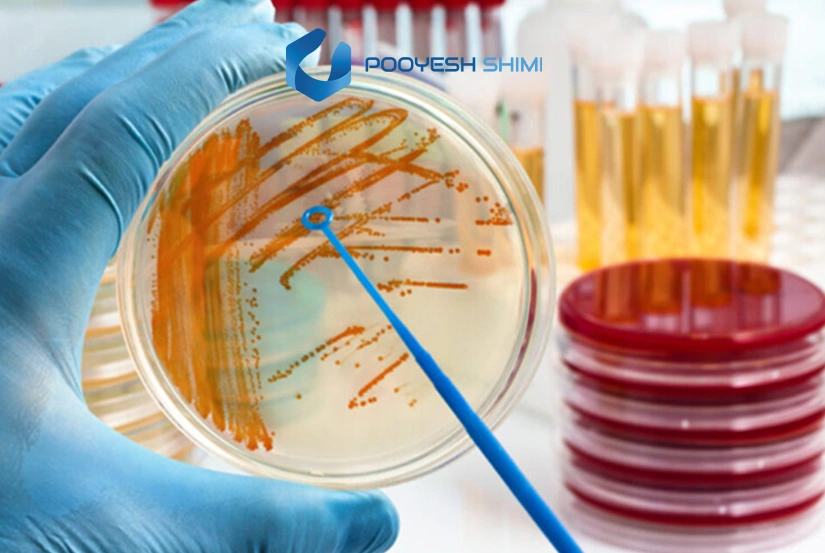
عوامل آلودگی محیط کشت چیست ؟
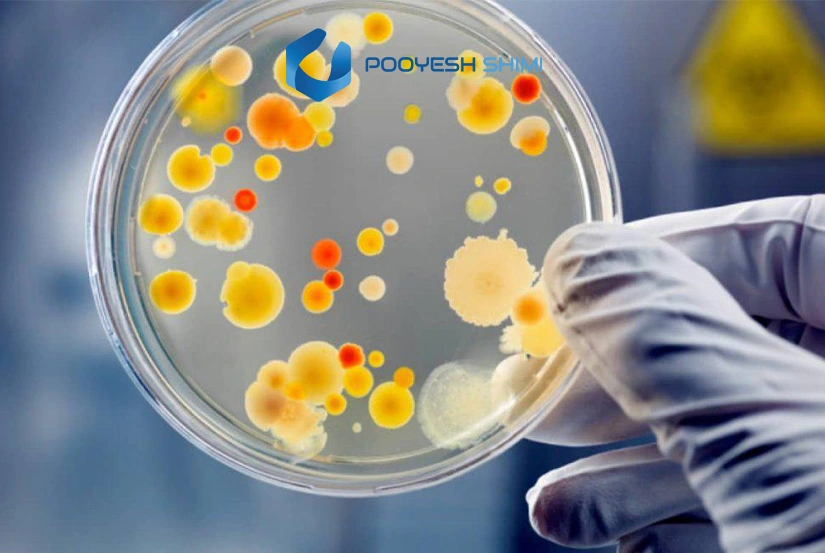
بررسی عوامل آلودگی محیط کشت

عوامل آلودگی محیط کشت چه تأثیری بر کیفیت محصولات کشاورزی دارند؟ عوامل آلودگی محیط کشت می توانند سلامت گیاهان را تحت تأثیر قرار دهند و رشد آن ها را کاهش دهند. این عوامل شامل آلودگی هوا، خاک و آب هستند که به مرور زمان بازدهی و کیفیت محصولات کشاورزی را کاهش می دهند. مدیریت صحیح منابع و کاهش آلاینده ها می تواند اثرات منفی این عوامل را به حداقل برساند.
آلودگی محیط کشت یکی از مشکلات اساسی و چالش برانگیز در صنعت کشاورزی است که می تواند تأثیرات جدی بر روی کیفیت محصولات، سلامت گیاهان، و به طور کلی بر اکوسیستم کشاورزی داشته باشد.
زمانی که به عوامل آلودگی محیط کشت فکر می کنیم، معمولاً به آلودگی های شیمیایی و صنعتی می پردازیم، اما باید بدانیم که آلودگی در این بخش ها فقط به مواد سمی محدود نمی شود. این آلودگی ها می توانند از منابع طبیعی و فعالیت های انسانی ناشی شوند و در بلندمدت اثرات منفی زیادی بر کشاورزی و محیط زیست بگذارند.
بررسی عوامل آلودگی محیط کشت
در این بخش به بررسی دقیق عوامل آلودگی محیط کشت می پردازیم و می کوشیم منابع و دلایل اصلی آلودگی را شناسایی کنیم. این بررسی شامل تاثیرات هوا، خاک، آب، سموم و فعالیت های انسانی بر کیفیت محیط کشت است. هدف، ارائه درکی جامع از چگونگی کاهش اثرات منفی و حفظ سلامت گیاهان و محصولات کشاورزی است. برای تجهیز آزمایشگاه های صنعتی، تحقیقاتی و دانشگاهی، می توانید از خدمات تجهیزات آزمایشگاهی پویش شیمی رسام البرز استفاده کنید.
انواع عوامل آلودگی محیط کشت کدام است؟
آلودگی محیط کشت می تواند به واسطه عوامل مختلفی رخ دهد که تاثیرات منفی بر رشد و تکثیر موجودات زنده در آن محیط دارند. مهمترین عوامل آلودگی شامل میکروارگانیسم های بیماری زا مانند باکتری ها، قارچ ها و ویروس ها هستند که می توانند از طریق هوا، ابزار آلوده، دست های ناپاک، یا حتی آبیاری آلوده به محیط کشت منتقل شوند.
علاوه بر این، آلودگی های شیمیایی ناشی از سموم، کودهای شیمیایی و مواد ضدعفونی کننده نادرست نیز می توانند بر کیفیت محیط کشت تاثیر بگذارند. در برخی موارد، آلودگی فیزیکی مانند گرد و غبار، ذرات معلق و آلودگی های ناشی از نشت مواد زائد نیز در محیط کشت مشاهده می شود که موجب کاهش عملکرد گیاهان و یا از بین رفتن آنها می شود. در ادامه به 8 مورد از عوامل آلودگی محیط کشت می پردازیم.
1. آلودگی هوا
یکی از نخستین و شناخته شده ترین عوامل آلودگی محیط کشت، آلودگی هوا است. گازهای سمی ناشی از فعالیت های صنعتی، حمل ونقل، و حتی فعالیت های کشاورزی، می توانند هوای محیط کشت را آلوده کنند. ذرات معلق، دی اکسید گوگرد، اکسیدهای نیتروژن و سایر گازهای آلاینده از مهم ترین آلودگی هایی هستند که در هوا پراکنده می شوند و می توانند باعث آسیب به گیاهان و کاهش میزان فتوسنتز آن ها شوند. این آلودگی ها باعث می شود گیاهان نتوانند به درستی رشد کنند و در برابر بیماری ها و آفات آسیب پذیرتر شوند.
هوای آلوده همچنین می تواند با تغییرات در دمای محیط، موجب استرس گرمایی برای گیاهان شود. در شرایطی که گیاهان در معرض این آلودگی ها قرار می گیرند، ممکن است در فرایند جذب مواد مغذی و آب دچار مشکل شوند، که در نهایت منجر به کاهش کیفیت محصولات می شود.
2. آلودگی خاک
آلودگی خاک از دیگر عوامل مهم آلودگی محیط کشت است. استفاده بیش از حد از مواد شیمیایی مانند کودهای شیمیایی و سموم آفت کش، می تواند باعث آلودگی خاک شود. این مواد شیمیایی به راحتی در خاک جمع می شوند و به مرور زمان کیفیت آن را کاهش می دهند. خاک آلوده نه تنها برای رشد گیاهان مناسب نیست بلکه می تواند منابع آب زیرزمینی را نیز آلوده کند. به ویژه در کشاورزی صنعتی که مقدار زیادی سموم و کود شیمیایی به خاک افزوده می شود، این مشکل تشدید می شود.
آلودگی خاک با اثرات منفی بر روی موجودات زنده ای که در خاک زندگی می کنند، از جمله کرم ها و میکروارگانیسم ها، می تواند باعث کاهش تنوع زیستی شود و توانایی خاک را برای حفظ سلامت گیاهان مختل کند. علاوه بر این، خاک آلوده می تواند به رشد ناقص گیاهان منجر شود و کیفیت محصولات کشاورزی را به طور چشمگیری کاهش دهد.
3. آلودگی آب
آب یکی از منابع حیاتی برای رشد گیاهان است. به همین دلیل، آلودگی منابع آب می تواند تأثیرات بسیار منفی بر محیط کشت داشته باشد. منابع آبی ممکن است به دلیل ورود مواد شیمیایی و سموم، فاضلاب های صنعتی، یا آلودگی های ناشی از فعالیت های کشاورزی آلوده شوند. این آلودگی ها می توانند از طریق ریشه های گیاهان به محصولات کشاورزی منتقل شوند، که این امر باعث کاهش کیفیت و سلامت محصولات می شود.
آلودگی آب می تواند بر روی اکوسیستم های آبی اطراف نیز تأثیر منفی بگذارد و تنوع زیستی موجودات دریایی و آبی را کاهش دهد. از طرفی، آب آلوده می تواند موجب انتشار بیماری ها و آفات شود که خود عامل دیگری در کاهش تولیدات کشاورزی است.
4. استفاده بی رویه از سموم و کودها
یکی از عوامل اصلی آلودگی محیط کشت، استفاده بیش از حد از سموم و کودهای شیمیایی است. در کشاورزی صنعتی، برای مقابله با آفات و بیماری ها و همچنین به منظور افزایش محصول، کشاورزان به طور مکرر از سموم شیمیایی و کودهای نیتروژنی استفاده می کنند. در حالی که این مواد می توانند به سرعت نتایج مطلوبی به ارمغان بیاورند، اثرات بلندمدت آن ها بر محیط کشت بسیار مخرب است.
باقی مانده این سموم و کودها در محصولات کشاورزی می توانند باعث آلودگی غذایی شوند و خطراتی برای سلامت انسان ها و حیوانات به همراه داشته باشند. همچنین، این مواد می توانند به خاک و منابع آبی نفوذ کنند و در طول زمان کیفیت محیط زیست را تحت تأثیر قرار دهند. اگر به محصولات تخصصی نیاز دارید، میتوانید از بخش محیط کشت میکروبی بهترین گزینه ها را تهیه کنید.
5. آلودگی ناشی از ضایعات کشاورزی
ضایعات کشاورزی، شامل بقایای گیاهان و سایر مواد زائدی هستند که در فرایند کشت، برداشت و فرآوری محصولات کشاورزی تولید می شوند. این ضایعات می توانند به صورت غیرمدیریت شده وارد محیط زیست شوند و موجب آلودگی خاک و آب شوند. علاوه بر این، ضایعات کشاورزی در صورت عدم مدیریت صحیح می توانند باعث انتشار گازهای گلخانه ای مانند متان شوند که تأثیرات منفی بر تغییرات اقلیمی دارد.
در حالی که ضایعات کشاورزی به خودی خود تهدیدی برای محیط کشت نیستند، مدیریت ضعیف آن ها می تواند مشکلات عمده ای ایجاد کند. با تبدیل ضایعات به کمپوست یا استفاده از آن ها در فرآیندهای تولید انرژی می توان از آن ها به نحو بهینه تری استفاده کرد.
6. تغییرات اقلیمی و دمای محیط
تغییرات اقلیمی از عوامل اساسی است که بر آلودگی محیط کشت تأثیر می گذارد. تغییرات در الگوهای بارش، افزایش دما و تغییرات در رطوبت هوا می تواند به طور مستقیم بر شرایط کشت و تولید محصولات کشاورزی تأثیر بگذارد. به عنوان مثال، افزایش دما باعث تبخیر بیشتر آب از خاک می شود و رطوبت آن را کاهش می دهد. این تغییرات اقلیمی می تواند منجر به کاهش کیفیت و کمیت محصولات کشاورزی و همچنین افزایش ریسک ابتلا به بیماری ها و آفات گردد.
7. آلودگی ناشی از فعالیت های صنعتی
فعالیت های صنعتی می توانند به عنوان یکی از مهم ترین عوامل آلودگی محیط کشت شناخته شوند. این فعالیت ها می توانند شامل تولید گازهای سمی، مواد شیمیایی، فلزات سنگین و ضایعات صنعتی باشند که به خاک، آب و هوا منتقل می شوند. این آلاینده ها می توانند به محیط کشت آسیب جدی وارد کنند و موجب کاهش کیفیت خاک و منابع آبی شوند.
فعالیت های صنعتی همچنین می توانند موجب از بین رفتن منابع طبیعی مانند جنگل ها و مراتع شوند که به نوبه خود بر اکوسیستم کشاورزی تأثیر منفی می گذارد.
8. آلودگی ناشی از حمل ونقل و ترافیک
حمل ونقل یکی دیگر از عوامل آلودگی محیط کشت است. گازهای آلاینده ای که توسط خودروها و وسایل نقلیه سنگین تولید می شوند، می توانند به هوا وارد شوند و بر کیفیت هوای محیط کشت تأثیر بگذارند. همچنین، ترافیک می تواند به تخریب زیستگاه های طبیعی و از بین رفتن اراضی کشاورزی منجر شود. این عوامل نه تنها بر کیفیت محیط کشت تأثیر می گذارند، بلکه می توانند بر سلامت گیاهان و محصولات کشاورزی نیز آسیب برسانند.
توضیحات تکمیلی عوامل آلودگی محیط کشت
در نهایت، آلودگی محیط کشت یک چالش جدی برای کشاورزی و محیط زیست است. عوامل مختلفی همچون آلودگی هوا، خاک، آب، استفاده بیش از حد از سموم و کودهای شیمیایی، تغییرات اقلیمی و فعالیت های صنعتی می توانند به کاهش کیفیت محصولات کشاورزی و آسیب به محیط زیست منجر شوند.
برای مقابله با این مشکلات، نیاز است که کشاورزی به سمت روش های پایدار و دوستدار محیط زیست پیش برود و از ابزارهای نوین مدیریت منابع برای حفاظت از محیط کشت بهره برداری کند.
تماس با ما | پویش شیمی
ما در پویش شیمی رسام البرز همواره آماده ایم تا به شما در ارائه راهکارهای بهینه در زمینه محصولات و خدمات شیمیایی کمک کنیم. اگر سوالی دارید یا نیاز به مشاوره دارید، لطفاً با ما در تماس باشید. تیم پشتیبانی ما در اسرع وقت پاسخگوی شما خواهد بود.